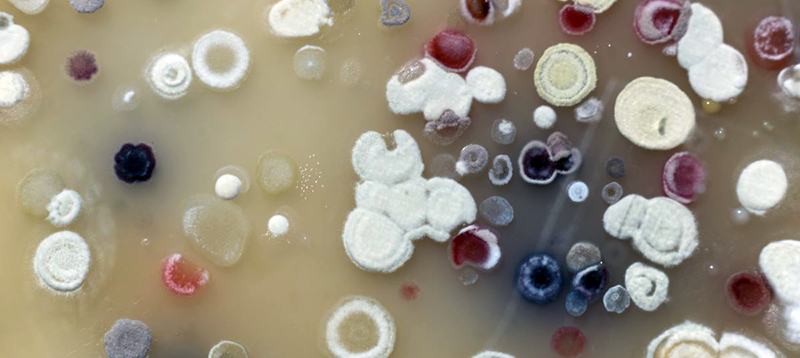

De bobos, actinos, islas y tesoros ocultos
Noemi Matías1, Teresa González2, Juan E. Martínez1, Oscar Téllez2 y Salvador Rodríguez2

Isla Clarión, en el Archipiélago de Revillagigedo, alberga especies únicas, en donde las aves marinas y bacterias son clave en el ciclo de nutrientes, las interacciones ecológicas y el mantenimiento de la biodiversidad.
Las islas han sido fuente de inspiración para historias de aventura desde hace mucho tiempo. En el imaginario de la gente, las islas albergan tesoros ocultos que aguardan la llegada de audaces exploradores. La realidad, no es tan lejana de la ficción, aun en el siglo XXI se logran encontrar tesoros ocultos en islas distantes, tesoros invisibles que se encuentran en el interior de pequeños organismos: los recursos genéticos de la biodiversidad.

Actinobacterias del suelo. Imagen: Mateusz Kropiwnicki
Isla Clarión es una isla ubicada en el océano Pacífico a 1100 km al oeste del puerto de Manzanillo (Colima), es una de las cuatro islas del Archipiélago de Revillagigedo. Aunque pequeña, de aproximadamente 8 km de longitud por 3 km de ancho, es habitada por una sorprendente diversidad de plantas, reptiles y aves endémicas.
En isla Clarión anidan colonias de aves marinas, como los pájaros bobos (Sula spp.). El principal alimento de estas aves son los pecesque por su tipo de alimentación son ricos en nitrógeno. Cuando las aves defecan, el nitrógeno ingresa al suelo en forma de guano, y de ahí las plantas lo pueden tomar para su nutrición. Este circuito conformado por los pájaros bobos, los peces y las plantas no estaría completo y no podría funcionar sin la presencia y actividad de las bacterias del suelo, que participan de manera fundamental en la recirculación del nitrógeno dentro de las redes tróficas.
Las bacterias, constituyen una de las formas de vida más diversas en nuestro planeta. Se estima que hay millones de especies en la Tierra, pero la mayoría aún espera a ser descubierta. La principal limitante es su tamaño microscópico y a sus necesidades específicas de cultivo e identificación, la cuales, en la mayoría de los casos, ignoramos. Hasta el momento, se ha logrado cultivar cerca del 1% de los microorganismos presentes en el suelo del planeta. Entonces, el 99% de estos microorganismos permanecen sin identificar.


Bobo y su cria en Isla Clarión. Imagen: Noemí Matías Ferrer
Pero las bacterias no solo son diversas en cuanto al número de especies, sino también en la diversidad funcional y de interacciones ecológicas que establecen con otros micro y macroorganismos. La diversidad funcional se refiere a los procesos ecosistémicos en los cuales participan las bacterias, por ejemplo, en la degradación de la materia orgánica. Mientas que, la diversidad de interacciones son las relaciones que establecen con otras poblaciones de múltiples especies, por ejemplo, de depredación (las bacterias son las presas favoritas de los protozoos) o mutualismo (transforman el nitrógeno que está en la atmósfera en compuestos que las plantas pueden utilizar).
En isla Clarión la diversidad de bacterias cultivables ha mostrado una dominancia de Actinobacterias, particularmente del género Streptomyces. Las Actinobacterias contribuyen con la degradación de la materia orgánica que llega al suelo, lo que favorece el reciclaje de nutrimentos para que las plantas puedan tener acceso a ellos. Por otro lado, también forman parte de un grupo de microorganismos que ha sido ampliamente estudiado con fines de uso biotecnológico y de salud humana.
Los Streptomyces en los medios de cultivo desarrollan formas filamentosas similares a cabellos y es común que produzcan pigmentos de variados colores (rosáceos, rojos, amarillos grises y blancos) bastante llamativos. Pero los pigmentos no son lo único que producen; también sintetizan metabolitos secundarios con propiedades antibióticas, antifúngicas y antiparasitarias. Por ejemplo, la estreptomicina o la rapamicina. Esta última fue obtenida a partir de cultivos de Streptomyces hygroscopicus, bacteria aislada del suelo de la isla de Rapa Nui (Isla de Pascua, Chile, conocida por sus colosales cabezas de piedra). La rapamicina funciona como inmunosupresor eficaz en el tratamiento de algunos cánceres.
Isla Clarión. Imagen: Noemí Matías-Ferrer
Algunos de los linajes genéticos de los Streptomyces aislados de Isla Clarión han mostrado que en su mayoría son similares a las encontradas en el continente, igualmente asociadas con ambientes terrestres ricos en nitrógeno, lo que sugiere que estos Streptomyces han logrado colonizar la isla gracias a la intervención de aves marinas como los pájaros bobos.
Así, la pequeña Isla Clarión es en realidad un microcosmos en el vasto océano Pacífico, que nos muestra la maravilla de las interacciones biológicas. Desde las aves marinas hasta las diminutas bacterias del suelo, cada organismo contribuye a mantener el funcionamiento y el equilibrio de este ecosistema único. Un recordatorio de la frágil belleza de la vida en nuestro planeta y de los tesoros biológicos que aún quedan por descubrir.
1Red de Interacciones Multitróficas, INECOL
2Laboratorio de Ecología Microbiana, UBIPRO, FES Iztacala, UNAM.

